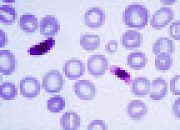

Anehdidunia.com – Setiap hal memiliki awal dan akhir….
Aneh Unik
Kuman Penyakit Ini Digunakan untuk Mengobati Penyakit Lain
Anehdidunia.com – Semua orang normalnya tidak mau kalau…

Mengejutkan! Operasi Pembedahan yang Sudah Dilakukan Manusia Sejak Era Kuno
Anehdidunia.com – Jika seseorang jatuh sakit, maka orang…

Hewan Berkemampuan Memakan Benda Keras
Manusia hanya bisa menelan makanan yang berbentuk lembut…

Seram! Thomas Alva Edison Pernah Coba Ciptakan Alat Menelepon Arwah Orang Mati
Anehdidunia.com – Thomas Alva Edison adalah salah satu…

Deretan Raja Dengan Masa Jabat Kekuasaan Tersingkat Sepanjang Masa
Anehdidunia.com – Menjadi raja sepintas terlihat menyenangkan. Padahal…

Kisah Violet Jessop, Terjebak Dalam Kapal Tenggelam Dan Selalu Berhasil Selamat
Anehdidunia.com – Violet Jessop nama dari seorang wanita…
Hal Aneh yang Dilakukan Manusia Pada Tangan Orang Mati
Anehdidunia.com – Saat seseorang sudah meninggal, maka mayat…

Meteorit Jatuh Ke Bumi Paling Berbahaya Bagi Manusia
Anehdidunia.com – Setiap harinya, ada begitu banyak benda…

Fakta dan Sejarah Unik Tentang Topi Yang Kamu Mungkin Pernah Pakai
Anehdidunia.com – Topi adalah aksesoris yang biasa digunakan…
No More Posts Available.
No more pages to load.






